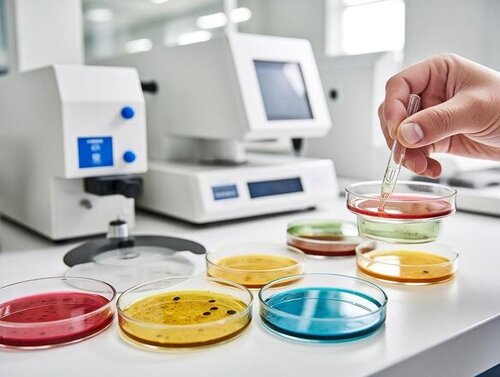
微生物检测

食品与农产品领域服务项目
Service Items
营养成分分析
农药残留检测
重金属检测
微生物检测
转基因成分鉴定
冷链运输验证

微析营养成分分析服务
在食品与农产品检测领域,营养成分分析是关键环节,主要检测蛋白质、脂肪、碳水化合物、维生素、矿物质等成分。通过科学方法准确测定含量,确保标签信息真实,为膳食搭配、产品研发及食品安全监管提供数据支撑,保障消费者知情权与健康需求。
该分析助力食品营养声称合规,为农产品品质评估和产业升级提供依据,是连接生产端与消费端的重要技术手段。
该服务由【微析技术研究院下属食品与农产品领域/营养成分分析】专项实验室承接。

微析农药残留检测服务
在食品与农产品检测领域,农药残留检测旨在测定样品中农药残留量,涵盖有机磷、氨基甲酸酯、拟除虫菊酯等多种类型。通过色谱、质谱等技术,排查是否超出限量标准,为农产品质量安全把控、风险评估及监管执法提供科学依据,守护消费者健康。
该检测是农产品入市关键关卡,助力杜绝超标产品流通,保障食品供应链安全,是落实食品安全监管的重要技术支撑。
该服务由【微析技术研究院下属食品与农产品领域/农药残留检测】专项实验室承接。

微析重金属检测服务
在食品与农产品检测领域,重金属检测聚焦铅、镉、汞、砷等有害元素,借助原子吸收光谱、电感耦合等离子体质谱等技术,测定其在样品中的含量。通过对比国家标准,排查是否超标,为农产品质量安全、风险预警及监管决策提供数据支持,守护消费安全底线。
该检测是食品供应链安全的重要防线,杜绝重金属超标产品流通,为食品安全监管提供关键技术保障。
该服务由【微析技术研究院下属食品与农产品领域/重金属检测】专项实验室承接。
微析微生物检测服务
在食品与农产品检测领域,微生物检测主要针对菌落总数、大肠菌群、沙门氏菌等致病微生物。通过培养、PCR等技术,测定其数量及存在状态,判断是否符合卫生标准,为食品生产卫生管控、风险评估及安全监管提供科学依据,防范食源性疾病风险。
该检测是保障食品安全性的核心手段,严格监控生产流通环节微生物污染,为食品安全防线筑牢技术支撑。
该服务由【微析技术研究院下属食品与农产品领域/微生物检测】专项实验室承接。

微析转基因成分鉴定服务
在食品与农产品检测领域,转基因成分鉴定通过PCR、基因测序等技术,检测样品中外源基因、重组蛋白等目标物质,判断是否含转基因成分。其为产品合规性判定、风险评估及监管政策实施提供技术依据,保障消费者知情权与产业健康发展。
该鉴定确保转基因食品标识真实合规,防范生物安全风险,是落实转基因监管要求的核心技术支撑。
该服务由【微析技术研究院下属食品与农产品领域/转基因成分鉴定】专项实验室承接。

微析冷链运输验证服务
在食品与农产品检测领域,冷链运输验证通过温度传感器、GPS追踪等技术,对运输过程中温度控制、设备性能及流程合规性进行检测。旨在确保冷链各环节温度达标,防范腐损变质风险,为农产品质量安全追溯与监管提供科学依据。
该验证保障冷链物流温控有效性,杜绝温度超标导致的品质问题,是食品供应链安全管控的关键技术环节。
该服务由【微析技术研究院下属食品与农产品领域/冷链运输验证】专项实验室承接。
食品与农产品领域相关标准
Relevant Standards
GB 5009.1-2016《食品安全国家标准 食品安全性毒理学评价程序》,规定了食品安全性毒理学评价的基本原则、内容和方法,适用于评价食品生产、加工、保藏、运输和销售过程中所涉及的可能对健康造成危害的化学、生物和物理因素的安全性。
GB 5009.22-2016《食品安全国家标准 食品中黄曲霉毒素B族和G族的测定》,明确了食品中黄曲霉毒素B₁、B₂、G₁、G₂的测定方法,包括高效液相色谱法、免疫亲和层析净化高效液相色谱法和酶联免疫吸附筛查法等。
GB 2763-2021《食品安全国家标准 食品中农药最大残留限量》,规定了食品中农药残留的最大限量要求,涵盖了多种农作物和农产品,是农产品中农药残留检测的重要依据。
GB/T 20769-2008《水果和蔬菜中450种农药及相关化学品残留量的测定 液相色谱-串联质谱法》,适用于水果和蔬菜中多种农药及相关化学品残留量的定性筛查和定量测定,具有较高的灵敏度和准确性。
GB 31658.17-2021《食品安全国家标准 动物性食品中四环素类、磺胺类和喹诺酮类药物残留量的测定 液相色谱-串联质谱法》,规定了动物性食品中这三类药物残留量的测定方法,适用于肉类、蛋类、乳制品等动物性农产品检测。
GB 5009.3-2016《食品安全国家标准 食品中水分的测定》,是食品中水分含量测定的通用标准,包括直接干燥法、减压干燥法、蒸馏法和卡尔·费休法等多种测定方法。
GB 2760-2014《食品安全国家标准 食品添加剂使用标准》,规定了食品添加剂的使用原则、允许使用的食品添加剂品种、使用范围及最大使用量或残留量,是食品添加剂检测的重要参考。
GB 4789.2-2022《食品安全国家标准 食品微生物学检验 菌落总数测定》,明确了食品中菌落总数的检验方法,用于判定食品被细菌污染的程度及卫生质量。
GB 5009.12-2017《食品安全国家标准 食品中铅的测定》,规定了食品中铅的测定方法,包括石墨炉原子吸收光谱法、火焰原子吸收光谱法、电感耦合等离子体质谱法和二硫腙比色法等。
NY/T 761-2008《蔬菜和水果中有机磷、有机氯、拟除虫菊酯和氨基甲酸酯类农药多残留的测定》,适用于蔬菜和水果中多种农药残留的测定,分为有机磷类农药测定、有机氯和拟除虫菊酯类农药测定、氨基甲酸酯类农药测定三部分。
GB 14880-2012《食品安全国家标准 食品营养强化剂使用标准》,规定了食品营养强化剂的使用原则、允许使用的营养强化剂品种、使用范围及使用量,为食品营养强化剂的检测和监管提供依据。
GB 4789.3-2016《食品安全国家标准 食品微生物学检验 大肠菌群计数》,制定了食品中大肠菌群的计数方法,包括大肠菌群平板计数法和大肠菌群MPN计数法,用于评估食品的卫生状况。
GB/T 22288-2008《牛奶和奶粉中氯霉素残留量的测定 气相色谱-质谱法》,适用于牛奶和奶粉中氯霉素残留量的测定,是乳制品中氯霉素残留检测的重要方法。
GB 5009.11-2014《食品安全国家标准 食品中总砷及无机砷的测定》,规定了食品中总砷和无机砷的测定方法,包括氢化物发生原子荧光法、原子吸收光谱法、电感耦合等离子体质谱法等。
NY/T 2015-2011《畜禽产品中四环素类、磺胺类和喹诺酮类药物残留量的测定 液相色谱-串联质谱法》,适用于畜禽产品中这三类药物残留量的测定,为畜禽产品质量安全检测提供技术支持。
GB/T 31740.1-2015《食用菌中农药残留测定 第1部分:503种农药及其代谢物残留量的测定 气相色谱-质谱和液相色谱-质谱串联法》,规定了食用菌中多种农药及其代谢物残留量的测定方法,适用于食用菌产品的农药残留检测。
QB/T 4574-2013《蜂蜜中四环素类药物残留量的测定 液相色谱-串联质谱法》,适用于蜂蜜中四环素类药物残留量的测定,为蜂蜜产品的质量安全检测提供了具体的方法和标准。
GB 5009.24-2022《食品安全国家标准 食品中霉菌毒素的测定》,整合了食品中多种霉菌毒素的测定方法,包括黄曲霉毒素、赭曲霉毒素A、展青霉素等,是霉菌毒素检测的重要国家标准。
GB/T 18969-2003《饲料中黄曲霉毒素B1的测定 高效液相色谱法》,虽然针对饲料,但饲料作为农产品生产的投入品,其检测标准对农产品质量安全追溯具有重要参考意义,规定了饲料中黄曲霉毒素B1的高效液相色谱测定方法。
GB 5009.190-2014《食品安全国家标准 食品中指示性多氯联苯含量的测定》,规定了食品中指示性多氯联苯(PCB28、PCB52、PCB101、PCB118、PCB138、PCB153、PCB180)含量的测定方法,适用于各类食品中多氯联苯残留的检测。
食品与农产品领域技术领域
Technical Field
解决方案
色谱分析法:通过色谱柱分离样品组分,结合检测器(如紫外、荧光)定量定性,可检测农药残留、食品添加剂等。气相色谱适用于挥发性物质,液相色谱适合高沸点、热不稳定成分,是检测复杂基质中痕量污染物的常用技术。
光谱分析法:利用物质对光的吸收、发射特性检测,如紫外-可见光谱测重金属、农药;红外光谱分析有机成分;原子吸收/荧光光谱精准测定铅、镉等重金属,具有快速、非破坏性特点,适合批量筛查。
质谱分析法:将样品离子化后按质荷比分离,结合色谱(如LC-MS、GC-MS)定性定量,可检测兽药残留、真菌毒素等。高灵敏度和特异性使其成为痕量污染物确证的“金标准”,尤其适用于多组分同时分析。
微生物检测法:通过培养计数、生化鉴定或分子生物学技术(如PCR)检测菌落总数、致病菌(沙门氏菌、大肠杆菌等)。传统培养法耗时较长,现代快速检测技术(免疫荧光、生物芯片)可缩短检测周期,保障食品安全。
理化分析法:基于物理化学性质检测,如滴定法测酸度、水分;重量法测杂质含量;电化学法(电极法)测pH、重金属离子。操作简便、成本低,是基础质量指标(如水分、灰分、酸价)检测的常规手段。
免疫分析法:利用抗原抗体特异性结合,如酶联免疫吸附试验(ELISA)、免疫层析试纸条,快速检测兽药残留(氯霉素)、过敏原等。灵敏度高、操作便捷,适合现场筛查和大规模初步检测,部分项目可15分钟内出结果。
分子生物学法:基于核酸序列检测,如PCR技术扩增目标基因,结合荧光探针(qPCR)定量转基因成分、致病微生物。可突破传统培养限制,对死菌/活菌核酸检测,广泛应用于转基因食品监管和病原微生物溯源。
快速检测技术:包括便携式仪器(拉曼光谱仪)、试纸条、生物传感器等,针对农药残留(酶抑制法)、亚硝酸盐等项目,实现现场快速定性/半定量。特点是耗时短(几分钟到半小时)、易操作,适合基层监管和前置筛查。
感官分析法:通过人体感官(视觉、嗅觉、味觉)评价食品色泽、气味、质地等,结合统计方法量化结果。常用于农产品新鲜度、加工食品品质分级,需培训专业评价员,是仪器检测无法替代的主观质量评估手段。
同位素分析法:利用同位素比值(如碳、氮稳定同位素)鉴别食品产地、原料真伪(蜂蜜掺假、肉类来源)。通过质谱测定同位素丰度差异,建立指纹图谱,为农产品溯源和防伪提供科学依据,属高端确证技术。
服务用途
食品与农产品检测可保障消费安全,通过对农药残留、兽药残留、重金属、致病微生物等有害物质的检测,排查食品与农产品中可能威胁人体健康的风险因素,为消费者饮食安全筑起防线,降低食源性疾病发生概率。
其能确保产品质量达标,对食品的营养成分、感官指标、理化性质及农产品的外观、口感、新鲜度等进行检测,判断是否符合国家标准、行业规范或企业质量要求,保障市场流通产品的品质稳定性。
在进出口贸易中发挥关键作用,针对国际通行的检测标准和进口国要求,对食品与农产品的安全性、成分合规性等进行检测,帮助企业规避贸易壁垒,确保产品顺利进入国际市场,维护国家贸易信誉。
可助力生产过程管控,对原材料采购、加工环节、成品储存等全流程进行检测监控,及时发现生产过程中的污染隐患或工艺缺陷,指导企业优化生产流程,提升质量管理水平,降低不合格产品产出率。
为政府监管提供技术支撑,通过对市场上食品与农产品的抽检和风险监测,形成数据报告供监管部门参考,协助制定针对性监管政策,打击违法添加、虚假标注等违规行为,维护市场秩序。
有助于农产品品质分级,依据检测结果对农产品的等级、优劣进行划分,如水果的糖度、硬度,谷物的蛋白质含量等,为农产品的定价、分类销售提供科学依据,促进优质优价市场机制形成。
可防范新兴风险隐患,针对新技术应用(如转基因食品)、环境变化(如土壤污染影响农产品)或新型污染物(如持久性有机污染物)开展检测研究,提前预警潜在风险,为产业健康发展提供前瞻性保障。
服务于企业品牌建设,通过第三方检测机构出具的权威检测报告,证明产品的安全性和高品质,增强消费者对品牌的信任度,提升产品市场竞争力,助力企业树立良好的质量口碑。
在突发事件应急处理中发挥作用,当出现食品安全事件(如食物中毒、污染事故)或农产品质量问题时,通过快速检测锁定问题来源和影响范围,为应急处置、召回管理和原因追溯提供关键技术支持。
推动产业升级与技术创新,检测过程中对先进检测方法和技术的需求,促使企业和科研机构加大在检测设备、标准研究等方面的投入,带动整个食品与农产品行业的技术进步和质量体系完善。
服务客户
+
出具报告
+
专业人员
+
实验仪器
+
微析服务优势
SERVICE ADVANTAGES

CMA/CNAS资质
微析技术研究院已经过严格的审核程序,同时获得了CMA/CNAS双资质认证,是一家专业正规的三方检测中心。

数据严谨精准
提供精准的数据支持,建立了完善的数据管理系统,对每个检测项目数据进行详细记录与归档,以便随时查阅追溯。

独立公正立场
严格按照法律法规和行业标准行事,不受任何外部干扰,真实反映实际情况,出具的检测报告具有权威性和公信力。

服务领域广泛
服务领域广泛,涉及众多行业。食品、环境、医药、化工、建筑、电子、机械等领域,都能提供专业检测服务。
检测服务流程
SERVICE PROCESS
只需四步
轻松解决需求




关于微析院所
ABOUT US WEIXI
微析研究所总部位于北京,拥有数家国内检测、检验(监理)、认证、研发中心,1家欧洲(荷兰)检验、检测、认证机构,以及19家国内分支机构。微析研究所拥有35000+平方米检测实验室,超过2000人的技术服务团队。
业务领域覆盖全国,专注为高分子材料、金属、半导体、汽车、医疗器械等行业提供大型仪器测试(光谱、能谱、质谱、色谱、核磁、元素、离子等测试服务)、性能测试、成分检测等服务;致力于化学材料、生物医药、医疗器械、半导体材料、新能源、汽车等领域的专业研究,为相关企事业单位提供专业的技术服务。
微析研究所是先进材料科学、环境环保、生物医药研发及CMC药学研究、一般消费品质量服务、化妆品研究服务、工业品服务和工程质量保证服务的全球检验检测认证 (TIC)服务提供者。微析研究所提供超过25万种分析方法的组合,为客户实现产品或组织的安全性、合规性、适用性以及持续性的综合检测评价服务。

十多年的专业技术积累

服务众多客户解决技术难题

每年出具十余万+份报告

2500+名专业技术人员

行业资讯动态
NEWS AND UPDATES
电子电气
环境领域
医疗器械
机械设备
食品农副
化学化工
汽车领域
建筑材料
能源电力
日常用品
生物医药
个护美妆
[06-30]
[06-30]
[06-30]
[06-30]
[06-30]
[06-30]
[06-30]
[06-30]
LED照明灯具安规认证中的电磁兼容测试是如何进行的检测标准是什么
[06-30]
[06-30]
[06-30]
[06-30]
[06-30]
[06-30]
更多资讯动态
MORE NEWS AND UPDATES
































































































